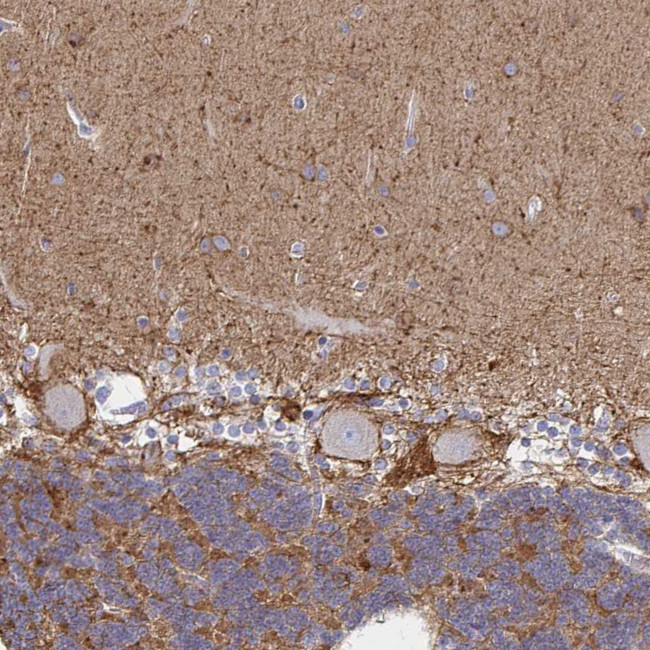
ATP1A3 Antibody in Immunohistochemistry (Paraffin) (IHC (P))

Search
Invitrogen
ATP1A3 Polyclonal Antibody
{{$productOrderCtrl.translations['antibody.pdp.commerceCard.promotion.promotions']}}
{{$productOrderCtrl.translations['antibody.pdp.commerceCard.promotion.viewpromo']}}
{{$productOrderCtrl.translations['antibody.pdp.commerceCard.promotion.promocode']}}: {{promo.promoCode}} {{promo.promoTitle}} {{promo.promoDescription}}. {{$productOrderCtrl.translations['antibody.pdp.commerceCard.promotion.learnmore']}}
产品信息
PA5-84291
种属反应
宿主/亚型
分类
类型
抗原
偶联物
形式
浓度
规格
纯化类型
保存液
内含物
保存条件
运输条件
RRID
产品详细信息
Immunogen sequence: EVAMTEHKMS VEEVCRKYNT DCVQGLTHSK AQE
Highest antigen sequence indentity to the following orthologs: Rat - 100%, Mouse - 100%.
靶标信息
The sodium/potassium ATPase is an integral membrane enzyme found in all cells of higher organisms and is responsible for the ATP-dependent transport of sodium and potassium across the cell membrane. This membrane-bound enzyme is related to a number of other ATPases including sarcoplasmic and endoplasmic reticulum calcium ATPase (SERCA) and plasma membrane calcium ATPase (PMCA). The sodium/potassium ATPase consists of a large, multipass, transmembrane catalytic subunit, termed the alpha subunit, and an associated smaller glycoprotein, termed the beta subunit. Studies indicate that there are three isoforms of the alpha subunit (alpha 1, alpha 2, alpha 3) and two isoforms of the beta subunit (beta 1 and beta 2) encoded by two multigene families. The different isoforms of the sodium/potassium ATPase exhibit tissue-specific and developmental patterns of expression. The alpha 1 and beta mRNAs are present in all cell types examined, whereas the alpha 2 and alpha 3 mRNAs exhibit a more restricted pattern of cell-specific expression. The alpha-3 subunit has been found in neuronal and to skeletal and cardiac muscle, lung and stomach tissues.
仅用于科研。不用于诊断过程。未经明确授权不得转售。
篇参考文献 (0)
生物信息学
蛋白别名: ATPase, Na+/K+ transporting, alpha 3 polypeptide; EC 3.6.3.9; Na(+)/K(+) ATPase alpha(III) subunit; Na(+)/K(+) ATPase alpha-3 subunit; Na+, K+ activated adenosine triphosphatase alpha subunit; Na+/K+ ATPase 3; Sodium Potassium ATPase; Sodium pump 3; Sodium pump subunit alpha-3; sodium-potassium ATPase catalytic subunit alpha-3; sodium-potassium-ATPase, alpha 3 polypeptide; sodium/potassium-transporting ATPase alpha-3 chain; Sodium/potassium-transporting ATPase subunit alpha-3; unnamed protein product
基因别名: AHC2; ATP1A1; ATP1A3; CAPOS; DEE99; DYT12; RDP
UniProt ID: (Human) P13637
Entrez Gene ID: (Human) 478